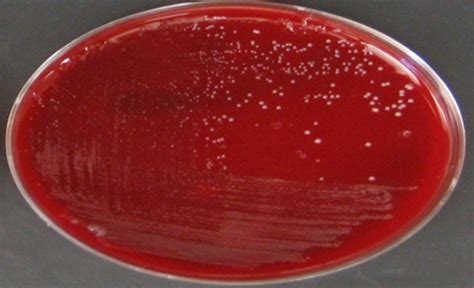

El acné vulgar es una enfermedad multifactorial del folículo pilosebáceo, en cuya patogenia se piensa que desempeña un papel importante el *Propionibacterium acnes*. La mayoría de los expertos aceptan actualmente que el *Propionibacterium acnes* no inicia dicha patología, pero contribuye a desencadenar el proceso inflamatorio que en ella se produce.

Lesiones típicas de acné vulgar
Durante mucho tiempo se han recetado en exceso antibióticos como tratamiento sintomático para el acné. Si bien pueden surgir beneficios a corto plazo, el uso excesivo de antibióticos recetados ha provocado que una población de pacientes sufra ahora resistencia a los antibióticos y trastornos de la salud intestinal.
Antibióticos en el Tratamiento del Acné
Los antibióticos han servido tradicionalmente como un componente fundamental del tratamiento del acné, por el papel que juega *Propionibacterium acnes* en su patogénesis. Los tratamientos usados en el acné que interfieren en el crecimiento y/o en el metabolismo del *Propionibacterium acnes* se pueden dividir en antibióticos y antimicrobianos no antibióticos.
Los antibióticos recetados con mayor frecuencia para el acné son la eritromicina y la clindamicina tópicas y las tetraciclinas orales, que son bacteriostáticos (inhiben el crecimiento bacteriano) en lugar de bactericidas (matan las bacterias). La exposición a agentes bacteriostáticos puede fomentar la aparición de cepas de *P. acnes* resistentes a los antibióticos.
A pesar de contar con una fuerza laboral relativamente pequeña en comparación con la población médica total, los dermatólogos prescriben antibióticos de manera desproporcionada. Esto ha llevado a un problema global de resistencia a los antibióticos con una prevalencia cada vez mayor con el tiempo.
Resistencia Antibiótica
Los pacientes con acné son un reservorio considerable de cepas resistentes que pueden ser transferidas a contactos cercanos no afectados de acné. La rápida inducción de resistencia a antibióticos del *Propionibacterium acnes*, acompañada de brotes de acné, ha sido descrita tras la aplicación de eritromicina y clindamicina tópicas, así como después de utilizar tetra-ciclina, eritromicina y doxiciclina sistémicas.
Los *Propionibacterium acnes* resistentes a la eritromicina y clindamicina fueron detectados por primera vez al final de los años setenta en Estados Unidos. Desde entonces se han detectado en el Reino Unido, Francia, Alemania, Japón y Nueva Zelanda, así como en otro centros de Estados Unidos.
SÚPER AYUDA #170 Acné, Un Síntoma De Un Grave Problema
No obstante, dos tipos de preparados con eritromicina son clínicamente efectivos en pacientes con *Propionibacterium acnes* resistentes, e incluso reducen el número de organismos resistentes en la superficie cutánea. Ambos preparados contienen dentro de la fórmula un segundo principio activo, el acetato de zinc o el peróxido de benzoilo que inhibiríanin vitro los *Propionibacterium acnes* resistentes a la eritromicina.
Los retinoides tópicos son igualmente activos frente a cepas resistentes y sensibles de *Propionibacterium acnes*. La isotretinoína también reduce considerablemente el número de *Propionibacterium acnes* resistentes en la piel de todos los pacientes.
Ahora tenemos ciencia que habla de la eficacia de apoyar un microbioma saludable tanto de forma tópica como interna. Los antibióticos deben reservarse para infecciones verdaderas donde no existen modalidades de tratamiento alternativas más seguras. El acné sigue siendo el problema número uno relacionado con la piel en los Estados Unidos y afecta a más de cincuenta millones de personas de todas las edades anualmente.
Estudio sobre Resistencia Antibiótica en Málaga
El objetivo de un estudio realizado en Málaga fue:
- Comprobar el grado de utilización de antibióticos tópicos y sistémicos por una población malagueña con acné.
- Cuantificar la tasa de resistencia del *Propionibacterium acnes* a cada antibiótico usado.
- Establecer comparación entre las tasas de resistencia de los distintos antibióticos usados.
Metodología
Se seleccionaron los 100 primeros pacientes consecutivos vistos en una consulta privada de un médico especialista en Dermatología. Todos ellos habían sido diagnosticados en los últimos 5 años de acné vulgar. Se citaron en dicha consulta en el mes de septiembre de 1999 explicándoles el motivo. De los 100 pacientes seleccionados, 7 no acudieron a la cita. Efectuamos una recogida de muestra en esos 93 pacientes con acné vulgar leve o moderado durante 1999. La toma fue realizada en pacientes de la provincia de Málaga y procesada en el laboratorio de la Universidad de Leeds (Reino Unido), con posterior cultivo en medios seleccionados para el *Propionibacterium acnes*. La toma de muestra y cultivo de nuestro trabajo fue realizada con el sistema utilizado rutinariamente en la clínica de acné del Skin Research Centre de Leeds.
Se utilizó la clasificación clínica habitualmente usada en España, que divide el acné vulgar en cuatro grados o estadios. Posteriormente se descartaron del estudio 5 pacientes con acné cuyo cultivo apareció contaminado por bacterias gramnegativas y/o levaduras, con lo que para el estudio se continuó con 88 pacientes.
Se realizó además una toma de muestra a 18 familiares de los pacientes con acné (padres, hermanos o hijos).
Se recogieron los siguientes datos de los pacientes: edad, sexo, tiempo de evolución desde el inicio del acné, grado de acné en el momento de la toma de la muestra, terapéutica tópica o sistémica usada en el momento del estudio o previamente, incluidos los diferentes antibióticos locales o sistémicos utilizados en el momento del estudio o con anterioridad a la toma de muestra.
Resultados del Estudio
Fueron estudiados 88 pacientes de los que 66 (75%) eran mujeres y 22 (25%) hombres. La edad media fue de 22,25 años, con edades comprendidas entre los 13 y los 35 años, siendo la edad más frecuente los 19 años. En más de la mitad de los casos (57%) el acné se había iniciado al menos 5 años antes. El grado de acné predominante fue el II (pápulo-pustuloso) en 57 pacientes (64,8%); 17 pacientes (19,3%) tuvieron un grado I, 5 pacientes (5,7%) un grado III y 9 pacientes (10,2%) estaban libres de acné en el momento de la toma de la muestra. No se estudió ningún paciente con un acné grado IV.
En el momento del estudio, 44 pacientes (50%) estaban siendo tratados con terapia combinada tópica y sistémica, 37 (42%) sólo con tratamientos tópicos y 7 (8%) no tenían ningún tratamiento en el momento de la toma. Ningún paciente se encontraba exclusivamente con tratamiento sistémico.
Dentro de los tratamientos tópicos usados tanto previamente como en el momento del estudio, el grupo hallado con mayor frecuencia (20%) fue el de los que utilizaron eritromicina tópica, exfoliantes (ácido retinoico, ácido glicólico y/o ácido salicílico) y un gel asociando eritromicina (3%) más peróxido de benzoilo (5%). La eritromicina sola o asociada la habían usado 85 pacientes (97,5%). La clindamicina fue usada por 18 pacientes (20,4%) en combinación con otros tratamientos tópicos. Ningún paciente la había usado sola.
Dentro de los tratamientos antibióticos sistémicos, 46 pacientes (52%) usaron la minociclina sola o asociada en algún momento. De ellos, 18 pacientes usaron exclusivamente la minociclina como tratamiento oral y 28 asociada a otros tratamientos. La doxicilina fue utilizada por 27 pacientes (10 de manera exclusiva y 17 asociada a otros tratamientos). Ningún paciente había utilizado eritromicina oral. La tetraciclina fue usada por 24 pacientes (2 de una manera exclusiva y 22 asociada a otros tratamientos).
En cuanto a los antibióticos usados, y con independencia de si lo eran de forma tópica o sistémica, con carácter previo o en el momento de la consulta el antibiótico más usado fue la eritromicina (85 pacientes; 70 en combinación con otros antibióticos y 15 sola). La minociclina la usaron 46 pacientes (45 de forma combinada y 1 sola); combinaban eritromicina y minociclina, 19 pacientes (22%).
El crecimiento de *Propionibacterium acne* (sin añadirle ningún antibiótico específico al medio de cultivo a excepción de la furazolidona) fue alto (3+) en el 56,8% de los casos. En un 17% el crecimiento fue bajo (1 +) y el 14,8% tuvo crecimiento intermedio (2+); en el 11,4% no creció nada (0+). En las placas en que añadimos eritromicina, el grupo más numeroso fue el de alta resistencia (3+) del *Propionibacterium acnes* al antibiótico (36,4%), el 25% tuvo un crecimiento bajo (1+), el 19,3% un crecimiento intermedio (2+) y el 19,3% no tuvo ningún crecimiento (0+). En aquellas placas en las cuales se añadió clindamicina, el grupo más numeroso (36,4%) tuvo un crecimiento alto del germen (3+), el 29,5% un crecimiento bajo (1+), el 15,4% un crecimiento intermedio (2+) y el 18,2% no tuvieron ningún crecimiento (0+). En las placas con tetraciclina como antibiótico, en la mayoría (95,5%) no creció *Propionibacterium acnes* (0+) y sólo en 4 pacientes (4,5%) hubo un crecimiento alto (3+). En el cultivo en el que utilizamos la minociclina llamó la atención que en 86 pacientes (97,7%) no creció nada (0+), mientras que en sólo 2 pacientes (2,3%) hubo un crecimiento alto (3+).
Resultados del cultivo (%) del Propionibacterium acnes en los distintos medios de cultivo.
En las muestras de los 18 contactos familiares de nuestros pacientes de acné (padres, hermanos o hijos) hubo un crecimiento alto de *Propionibacterium acnes*, sin añadir antibióticos específicos en 12 (66,7%); en 5 (27,8%) los cultivos con eritromicina dieron un crecimiento alto del germen y en 7 (38,9%) la clindamicina. Por el contrario, la tetraciclina nos dio un 94,4% de sensibilidad y la minociclina un 100%. Aunque evidentemente este grupo de contactos control es una muestra pequeña, los datos obtenidos pueden ser orientativos.
Discusión
*Propionibacterium acnes* es un factor más a tener en cuenta dentro de la etiopatogenia del acné y el hecho de encontrar este microorganismo resistente o sensible a los distintos antibióticos, como hemos presentado en nuestro trabajo, no implica necesariamente el éxito o fracaso en el tratamiento, ya que este microorganismo también se encuentra en la piel de sujetos sanos.
En un estudio realizado en Leeds se observó que uno de cada dos contactos más cercanos presentaba cepas resistentes. Esto nos deja una puerta abierta para investigar los contactos más íntimos en pacientes con acné, con una muestra más amplia y poder corroborar la transferencia de cepas resistentes a antibióticos de personas afectadas con acné a aquellas que no lo tienen.
Los datos presentados en el estudio confirman, tal y como recoge la literatura, un predominio de acné en el sexo femenino y una edad media en torno a los 22 años, observándose el incremento del acné en mujeres mayores de 20 años. El hecho de que en más de la mitad de los casos (57%) el acné se iniciara 5 años antes de comenzar el estudio, nos puede indicar que los tratamientos utilizados, y en nuestro caso los antibióticos tópicos y/o sistémicos, han sido usados durante largos períodos y por ende pueden haber contribuido a la formación de cepas resistentes de *Propionibacterium acnes*.
Es interesante subrayar que la mayor parte de los pacientes estudiados fueron del grado II, no pudiendo haber sido afectada la muestra por valores extremos (en la muestra no se recogió ningún caso de acné grado IV ni de acné noduloquístico). El hecho de que el antibiótico más usado en nuestro estudio, con un 97,5%, fuera la eritromicina puede hacernos pensar que realmente es el antibiótico más ampliamente utilizado en el acné por la población general, y esto se puede constatar por la historia clínica de nuestros pacientes, donde no solamente el médico de cabecera lo utiliza habitualmente, sino que el farmacéutico e incluso el propio paciente se lo automedica. Este uso continuado de la eritromicina podría ser un factor predisponente para el desarrollo de cepas resistentes de *Propionibacterium acnes*.
En este estudio se observó una resistencia alta del *Propionibacterium acnes* frente a la eritromicina en el 36,5% de los cultivos y una resistencia intermedia en el 19,3%; es decir, que en un 55,8% de los casos crecieron más de 51 colonias de *Propionibacterium acnes* en los cultivos con eritromicina. Esto coincide con la literatura, donde la eritromicina fue el antibiótico que creó más resistencia. La clindamicina tópica es otro antibiótico ampliamente utilizado en el acné desde hace años. Nuestro trabajo muestra que en un 51,8% de los cultivos con ese antibiótico crecieron más de 51 colonias, lo que significa que, si bien globalmente la eritromicina fue el antibiótico más resistente, la diferencia respecto a la clindamicina fue pequeña.
El grado de resistencia del *Propionibacterium acnes* obtenido en nuestro trabajo es mayor con las tetraciclinas clásicas que con la minociclina. El hecho de que en el 95,5% de los casos no hubiera ningún tipo de crecimiento bacteriano en los cultivos con tetraciclina puede hacernos pensar que la resistencia a las tetraciclinas es bastante baja, a pesar de ser uno de los primeros antibióticos usados para el tratamiento del acné y que es considerada aún como un tratamiento de primera elección. Sin embargo, en el Reino Unido y en Estados Unidos se están detectando cada vez más cepas de *Propionibacterium acnes* resistentes a diferentes tipos de tetraciclinas, además de a la eritromicina y a la clindamicina, reduciéndose de este modo el número de opciones terapéuticas.
Diferentes artículos son unánimes a la hora de catalogar la resistencia a la minociclina como extremadamente rara, lo que concuerda con nuestros resultados, donde un 97,7% de los cultivos con ese antibiótico fueron sensibles al mismo, siendo, por tanto, el antibiótico de elección dentro de las diferentes modalidades.
La etiología del acné es multicausal, aunque la participación de *Cutibacterium acnes* es relevante. Las lesiones pueden ser no inflamatorias (comedones, abiertos o cerrados), inflamatorias (pápulas, pústulas, nódulos o quistes) o residuales (máculas o cicatrices). El acné puede clasificarse según su intensidad en leve (predominancia de comedones, con pápulas escasas), moderado (predominancia de pápulas y pústulas, con comedones) y grave (presencia de nódulos inflamatorios y quistes).

Clasificación del acné según su gravedad.
La elección del tratamiento se hace en función del tipo de lesiones y su gravedad. El acné leve/moderado suele tratarse con productos tópicos. Los tratamientos tópicos actuales incluyen: derivados tópicos del ácido retinoico (tretinoína, adapaleno y tazaroteno), peróxido de benzoilo, ácido azelaico, antibióticos tópicos (eritromicina y clindamicina).
Los tratamientos orales se reservan para acné inflamatorio moderado o grave o que no responde a la terapia tópica y comprenden los antibióticos orales (fundamentalmente doxiciclina y minociclina) y la isotretinoína oral.
Las recaídas son frecuentes, por lo que la terapia de mantenimiento es un componente esencial en el tratamiento del acné. El acné vulgar es más frecuente en adolescentes y adultos jóvenes, aunque puede aparecer a edades más tempranas.
Resistencia bacteriana y Cutibacterium acnes
El uso de antibióticos tópicos y sistémicos para el acné causa resistencia bacteriana. Este trabajo de investigación asocia la formación de esta resistencia a la bacteria *Propionibacterium acnes* (*P. acnes*). La resistencia a los fármacos antibióticos es un problema global ya que el aumento de la prevalencia en el tiempo preocupa de manera considerable a médicos y científicos.
Generalmente, los más utilizados en esta enfermedad cutánea son la eritromicina tópica y clindamicina y tetraciclinas orales, que son bacteriostáticos (inhiben el crecimiento bacteriano), en lugar de bactericidas (que eliminan las bacterias). De esta forma, como bien recoge este estudio, la exposición a agentes bacteriostáticos puede estimular la aparición de cepas resistentes a los antibióticos de *P. acnes*.
Estas cepas de *P. acnes* pueden causar infecciones graves, por lo tanto, las prácticas de prescripción actuales pueden representar un riesgo para los contactos no tratados, especialmente aquellos con alteraciones frente a la inmunidad. En una cohorte retrospectiva de más de 100 000 pacientes con acné, los tratados con antibióticos tópicos y/o orales durante al menos 6 semanas fueron significativamente más propensos a desarrollar infecciones respiratorias durante el año de seguimiento que los pacientes que no habían recibido antibióticos.
En caso de acné, algunos tipos de *Cutibacterium acnes* desaparecen mientras que otros se vuelven predominantes. Esta pérdida de diversidad es un primer elemento a favor de la disbiosis. A su vez, otras bacterias de la familia de los estafilococos (principalmente S. epidermidis y también S. aureus) proliferan, acentuando el desequilibrio del microbioma.
Al mismo tiempo, *Cutibacterium acnes* ejerce una acción en las células encargadas de la producción del sebo y, por lo tanto, también influye en los fenómenos de acné retencional. Por consiguiente, el microbioma cutáneo interviene en las dos principales formas de acné, el acné inflamatorio y el acné retencional.
El desequilibrio del microbioma cutáneo va acompañado de la formación de biofilms: se trata de finas capas que aíslan las bacterias del exterior, permitiéndoles seguir creciendo y haciéndolas más resistentes a los tratamientos antibacterianos. También se ha demostrado que ciertas cepas de C. acnes pueden desempeñar su función en el grado de severidad del acné juvenil. Por lo tanto, es esencial respetar la diversidad del microbioma cutáneo, mantenerlo, y en el caso de los pacientes con acné, utilizar productos adaptados para RESTAURARLO.
Infecciones osteoarticulares por Cutibacterium
Cutibacteria (anteriormente propionibacteria) es parte de la flora normal de la piel humana y de las superficies de la mucosa. Son bacilos anaeróbicos de crecimiento lento, grampositivos, no móviles, de virulencia relativamente baja pero que es capaz de adherirse y formar biopelículas; esta característica juega un papel importante en la patogénesis de la infección debida a este organismo. En la mayoría de los pacientes con infecciones articulares protésicas Cutibacterium, se ha observado infiltración del glicocalix con adherencia a la superficie del implante.
Respecto a la clínica las infecciones osteoarticulares por este microorganismo se caracterizan por ser paucisintomáticas, con muy pocos signos inflamatorios y prácticamente sin elevación de los reactantes de fase aguda por ello el diagnóstico puede retrasarse meses o años Esto hace que la mayoría de infecciones por P.acnes son infecciones osteoarticulares crónicas o son hallazgos casuales al remitir muestras intraoperatorias de prótesis aflojadas a cultivar. Estos organismos pueden ser difíciles de identificar inicialmente debido a su lento crecimiento, especialmente en muestras clínicas que también contienen otros organismos comunes, fácilmente recuperables.
Por tanto puede ser difícil determinar si un cultivo positivo refleja contaminación o verdadera infección y los cultivos requieren condiciones de anaerobiosis y tiempos de incubación prolongados, además las infecciones polimicrobianas por ejemplo por S.epidermidis como en nuestro caso pueden impedir el crecimiento de las colonias de P.acnes. Algunos utilizan un protocolo de transporte anaeróbico y sonicación suave para liberar las bacterias adherentes.
Metaanálisis sobre Resistencia Antibiótica en Acné
El acné es una de las afecciones dermatológicas con mayor incidencia a nivel mundial; su origen es multifactorial y, por lo tanto, su tratamiento puede ser complejo. *Propionibacterium acnes* tiene un papel primordial en la inflamación de esta dermatosis y para su tratamiento se usan antibióticos tópicos; entre los principales se encuentran eritromicina y clindamicina, en los que se ha documentado una amplia resistencia bacteriana, lo que genera controversia respecto a su uso. Por este motivo se presenta un metaanálisis de las publicaciones de los últimos 10 años para confirmar esta hipótesis.
Se encontraron 13 artículos que cumplieron con los criterios de inclusión. La razón de momios promedio (OR 1.24, IC 95%) de los artículos demostró una ligera tendencia hacia la resistencia de *Propionibacterium acnes*.
Se confirma el aumento en la resistencia bacteriana de *Propionibacterium acnés* a eritromicina y clindamicina tópica, por lo que recomendamos el uso de estos antibióticos combinados en casos selectos por periodos cortos y en combinación con peróxido de benzoilo, para obtener el mejor resultado clínico en los pacientes con Acne vulgaris.
En los últimos años se ha hecho evidente la resistencia a los antibióticos tópicos en diferentes publicaciones, principalmente a la eritromicina y la clindamicina tópicas; sin embargo, en la práctica no se ha esclarecido completamente su significado clínico y se siguen usando como práctica común en el manejo de los pacientes, principalmente en aquellos con acné papulopustuloso. Al revisar la literatura podemos observar que son pocas las publicaciones que contienen criterios estrictos de demostración de la resistencia de P. acnes a los antibióticos tópicos; 7 artículos presentan una OR mayor a 1, lo cual muestra una tendencia a la resistencia bacteriana.
Eritromicina y clindamicina son los 2 antibióticos tópicos que todos los artículos prueban. En el caso de eritromicina, el porcentaje de resistencia promedio en todas las publicaciones es de un 30%, con un máximo de 73.6% en el estudio de Dumont-Wallon et al. El caso de clindamicina es similar, con un promedio de resistencia de un 25.5% y un máximo de 53% en el estudio de Luk et al.
Debemos resaltar que a pesar de que existe una tendencia estadística hacia la resistencia bacteriana, esta es muy débil y clínicamente puede haber fallo en el tratamiento tópico; sin embargo, se debe recordar que la combinación de los antibióticos tópicos con peróxido de benzoilo, como lo indican las guías de tratamiento, disminuye la incidencia de resistencia. Publicaciones recientes comprobaron que los pacientes con P. acnes resistente tienen un beneficio clínico si antes del tratamiento con el antibiótico tópico se realiza un lavado de la zona afectada, una vez al día con peróxido de benzoilo al 6% durante 20 s, lo que disminuye la resistencia bacteriana considerablemente (1 log después de una semana de tratamiento y al menos 2 log después de 3 semanas de tratamiento).
La monoterapia con clindamicina y eritromicina no debe ser la base para el tratamiento de esta afección; estos antibióticos tópicos se pueden utilizar en casos muy selectos, por periodos cortos, y siempre deben combinarse con peróxido de benzoilo para reducir, desinflamar y evitar la resistencia bacteriana de P. acnes.
| Dianas en el tratamiento del acné | Producción sebácea | Queratinización | Efecto bactericida | Inflamación |
|---|---|---|---|---|
| Peróxido de benzoilo | - | (+) | +++ | (+) |
| Retinoides | - | ++ | (+) | + |
| Clindamicina | - | (+) | ++ | - |
| Antiandrógenos | ++ | + | - | - |
| Ácido azelaico | - | ++ | ++ | + |
| Tetraciclinas | - | - | ++ | + |
| Eritromicina | - | - | ++ | - |
| Isotretinoina | +++ | ++ | ++ | ++ |
+++ efecto muy intenso; ++ efecto intenso; + efecto moderado; (+) efecto indirecto o leve; - sin efecto
tags: #propionibacterium #acnes #traitement #antibiotique